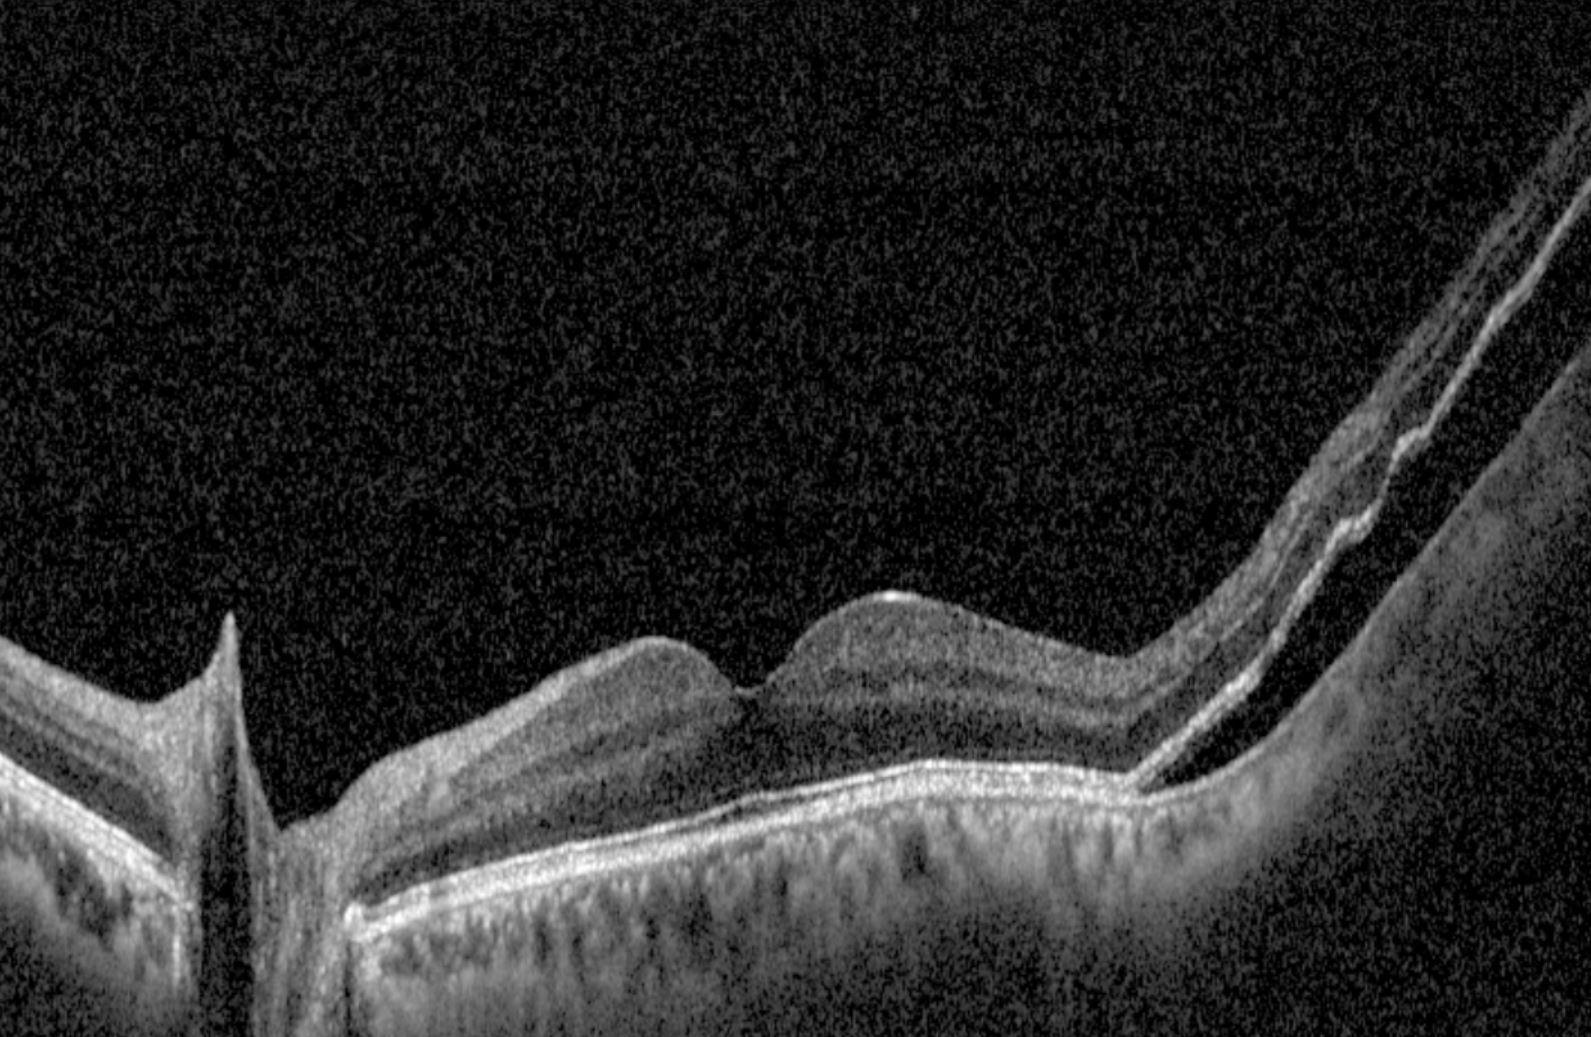

Patching Therapy for Amblyopia

If your child has amblyopia your optometrist may decide it is best to start occlusion therapy to try to improve the vision in the amblyopic eye. Patching forces your child to use the eye with worse vision.
Patches come in two varieties:
- Eze Patch - this re-useable patch is a soft fabric sleeve that sits snuggly over the child’s glasses. Make sure this sits closely over the good eye so the child cannot peek around the patch.
- Stick-on Patch - this is like a band-aid, but often colourful and fun. It should be placed over the eye and stuck on firmly to completely cover the eye.
Some key points about patching therapy:
- Put the patch on the eye with better vision.
- Unless advised otherwise, use the patch for 2 hours per day. This can be broken up into two different periods throughout the day, providing approximately 14 hours of patching are done per week.
- Your child will probably not like wearing the patch at first. This is quite normal. There are two reasons for this. Firstly, it is physically a little uncomfortable having the patch on. Secondly (and more importantly) we are forcing your child to use their weaker eye, so they do not see as well as they normally do. If the child has to wear glasses these should always be on during patching.
- We suggest you reward your child when they have worn the patch and complied with the patching schedule on each day. This is especially important for the first month. Praise is always appreciated, and we encourage you to do this, but a tangible reward such as a fun activity or toy will assist your child’s motivation.
- Try to get your child to do visually stimulating tasks such as playing a computer game, watching a TV show or reading a book while wearing the patch. This will also make the period fun for the child.
- It can be helpful to use a Patching Record Sheet. This is to be filled in and brought with you to your first follow-up visit with your optometrist. It allows us to see that the child is using the patch correctly so that the expected visual change occurs.
An Innovative Eye Care Patching Record Sheet can be downloaded here.
If you have any problems with the patching, please call and advise us at Innovative Eye Care.
Speak to our friendly team today
Book your appointment now for personalised eye care tailored just for you.